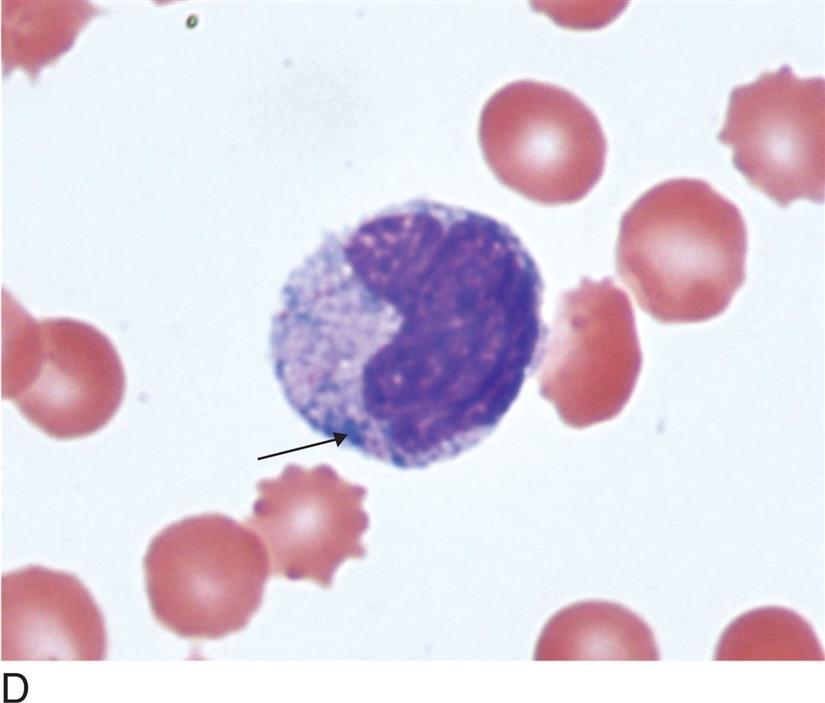
image
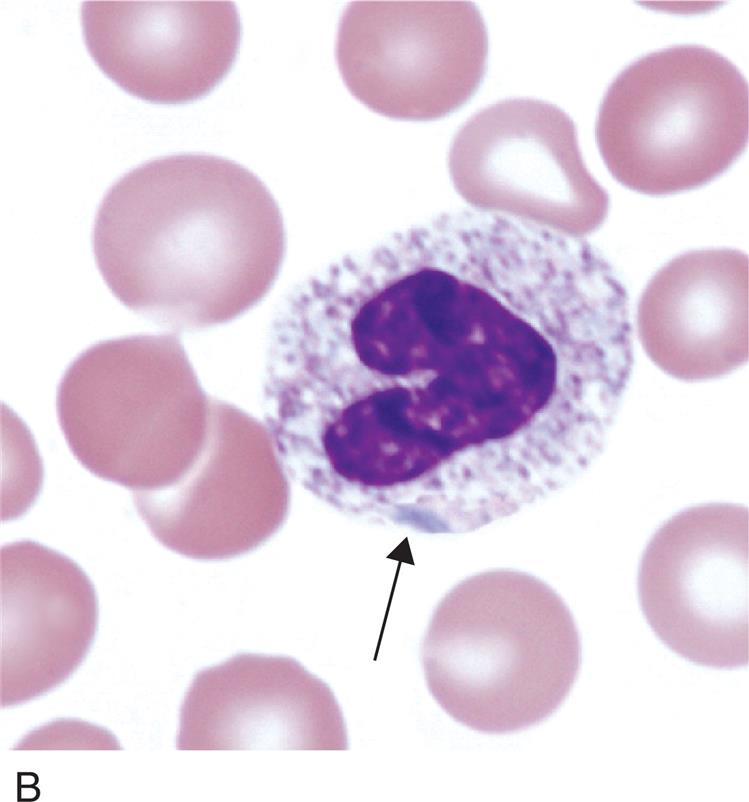
image
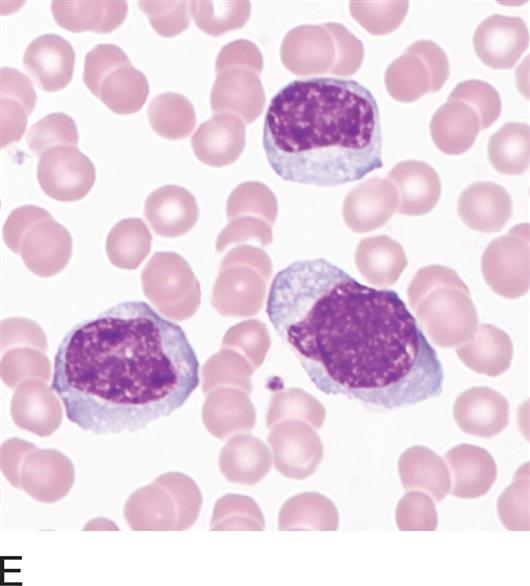
image

DESCRIPTION: Peanut-shaped, bilobed or non-segmented, granulocyte nucleus with the coarse chromatin of a mature cell
ASSOCIATED WITH: Pelger-Hüet anomaly, pseudo-Pelger-Hüet anomaly
NOTE: Pelger-Hüet anomaly is inherited and affects the majority of granulocytes. Pseudo-Pelger-Hüet is acquired, affects less than 50% of granulocytes, and is usually accompanied by other morphologic indications of malignancy, such as those seen in myeloproliferative or myelodysplastic disorders (see Chapter 17, Myeloproliferative Neoplasms and Chapter 18 Myelodyspastic Syndromes.).
DESCRIPTION: Six or more lobes in granulocyte nucleus
ASSOCIATED WITH: Megaloblastic anemias, chronic infections, myelodysplastic syndrome; rarely inherited
DESCRIPTION: Unstained circular area within the cytoplasm
NUMBER: Few to many
ASSOCIATED WITH: Bacterial or fungal infection, poisoning, burns, chemotherapy, artifact
NOTE: Vacuoles rarely may contain microorganisms or pigment. Vacuoles are seen in normal monocytes and do not suggest infection.
DESCRIPTION: Gray-blue, variably shaped inclusion in cytoplasm
COMPOSITION: Ribosomal RNA
NUMBER: Single or multiple
ASSOCIATED WITH: Wide range of conditions, including bacterial infection, sepsis, and normal pregnancy
NOTE: May be seen in cells with toxic granulation or on same slide with toxic granulation. (See Figure 14.5B.)

DESCRIPTION: Amorphous blue-green granules in cytoplasm of neutrophils
COMPOSITION: Lipid-rich, possibly lipofusion-like material
NUMBER: Single or multiple
ASSOCIATED WITH: Severe liver disease, lactic acidosis, sepsis
NOTE: Also known as the blue-green crystals of death.
DESCRIPTION: Prominent dark purple-black granules in the cytoplasm of neutrophils, unevenly distributed
COMPOSITION: Primary granules
NUMBER: Few to many
ASSOCIATED WITH: Wide range of conditions including bacterial infection, sepsis and following administration of granulocyte colony-stimulating factor
DESCRIPTION: Decreased number or absence of specific granules giving the cytoplasm a colorless appearance
ASSOCIATED WITH: Myelodysplastic syndrome, myeloproliferative neoplasms, infection
DESCRIPTION: 10 to 30 μm; pleomorphic; easily indented by surrounding cells
NUCLEUS: Irregular
Nucleoli: Occasionally present
Chromatin: When compared with that of a resting lymphocyte, chromatin is coarse to fine and dispersed
CYTOPLASM: Pale blue to deeply basophilic, may stain unevenly with peripheral or radial basophilia
Granules: May have increased numbers of azurophilic granules
Vacuoles: Occasional
ASSOCIATED WITH: Viral infections and other antigenic stimulation, including organ transplantation